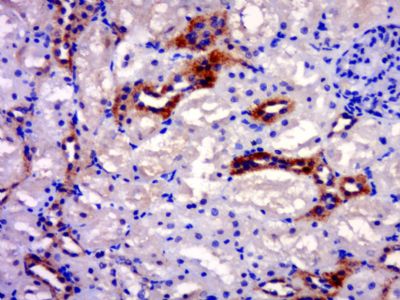
产品细节图片1

相关产品推荐更多 >
万千商家帮你免费找货
0 人在求购买到急需产品
- 详细信息
- 文献和实验
- 技术资料
- 供应商:
上海联迈生物工程有限公司
- 库存:
大量
- 目录编号:
LM-6178R
- 克隆性:
多克隆
- 抗原来源:
Rabbit
- 保质期:
1年
- 抗体英文名:
RAB20
- 抗体名:
ras癌基因家族RAB20抗体
- 宿主:
Rabbit
- 适应物种:
Human, Mouse, Rat, Chicken, Dog, Pig, Cow, Horse,
- 免疫原:
KLH conjugated synthetic peptide derived from human Rab20:131-234/234
- 亚型:
IgG
- 形态:
Lyophilized or Liquid
- 应用范围:
ELISA=1:500-1000 IHC-P=1:400-800 IHC-F=1:400-800 IF=1:100-500 (石蜡切片需做抗原修复)
- 浓度:
1mg/ml
- 保存条件:
Store at -20 °C
- 规格:
100ul 200ul
| 英文名称 | RAB20 |
| 中文名称 | ras癌基因家族RAB20抗体 |
| 别 名 | FLJ20429; RAB20; RAB20 member RAS oncogene family; RAB20_HUMAN; Ras related protein Rab20; Ras-related protein Rab-20. |
| 规格价格 | 100ul/1380元 购买 200ul/2200元 购买 大包装/询价 |
| 说 明 书 | 100ul 200ul |
| 研究领域 | 肿瘤 信号转导 细胞类型标志物 G蛋白信号 |
| 抗体来源 | Rabbit |
| 克隆类型 | Polyclonal |
| 交叉反应 | Human, Mouse, Rat, Chicken, Dog, Pig, Cow, Horse, |
| 产品应用 | ELISA=1:500-1000 IHC-P=1:400-800 IHC-F=1:400-800 IF=1:100-500 (石蜡切片需做抗原修复) not yet tested in other applications. optimal dilutions/concentrations should be determined by the end user. |
| 分 子 量 | 26kDa |
| 细胞定位 | 细胞浆 |
| 性 状 | Lyophilized or Liquid |
| 浓 度 | 1mg/ml |
| 免 疫 原 | KLH conjugated synthetic peptide derived from human Rab20:131-234/234 |
| 亚 型 | IgG |
| 纯化方法 | affinity purified by Protein A |
| 储 存 液 | 0.01M TBS(pH7.4) with 1% BSA, 0.03% Proclin300 and 50% Glycerol. |
| 保存条件 | Store at -20 °C for one year. Avoid repeated freeze/thaw cycles. The lyophilized antibody is stable at room temperature for at least one month and for greater than a year when kept at -20°C. When reconstituted in sterile pH 7.4 0.01M PBS or diluent of antibody the antibody is stable for at least two weeks at 2-4 °C. |
| PubMed | PubMed |
| 产品介绍 | background: The Ras-related superfamily of guanine nucleotide binding proteins includes the R-Ras, Rap, Ral/Rec and Rho/Rab subfamilies all of which are thought to play an important role in either endocytosis or in biosynthetic protein transport. The process of transporting newly synthesized proteins from the endoplasmic reticulum (ER) to various stacks of the Golgi complex and to secretory vesicles involves the movement of carrier vesicles and requires Rab protein function. Rab proteins are also an integral part of endocytic pathways. Rab 20 (Ras-related protein Rab-20) is a 234 amino acid protein that localizes to the golgi apparatus and belongs to the Rab subfamily of small GTPases. Expressed in normal and cancerous pancreatic tissue, Rab 20 plays an important role in apical endocytosis and recycling and may be involved in the development of exocrine pancreatic adenocarcinomas Function: Plays a role in apical endocytosis/recycling. Plays a role in the maturation and acidification of phagosomes that engulf pathogens, such as S.aureus and M.tuberculosis. Plays a role in the fusion of phagosomes with lysosomes. Subcellular Location: Golgi apparatus. Cytoplasmic vesicle, phagosome. Cytoplasmic vesicle, phagosome membrane; Lipid-anchor; Cytoplasmic side (By similarity). Note=Highly enriched on apical endocytic structures in polarized epithelial cells of kidney proximal tubules (By similarity). Recruited to phagosomes containing S.aureus or M.tuberculosis. Tissue Specificity: Low or absent expression in normal pancreas and stronger expression in 15 of 18 exocrine pancreatic adenocarcinomas (at protein level). Similarity: Belongs to the small GTPase superfamily. Rab family. SWISS: Q9NX57 Gene ID: 55647 Database links: Entrez Gene: 55647 Human SwissProt: Q9NX57 Human Unigene: 729392 Human Important Note: This product as supplied is intended for research use only, not for use in human, therapeutic or diagnostic applications. |
| 产品图片 | ![]() Paraformaldehyde-fixed, paraffin embedded (rat kidney); Antigen retrieval by boiling in sodium citrate buffer (pH6.0) for 15min; Block endogenous peroxidase by 3% hydrogen peroxide for 20 minutes; Blocking buffer (normal goat serum) at 37°C for 30min; Antibody incubation with (RAB20) Polyclonal Antibody, Unconjugated (bs-6178R) at 1:500 overnight at 4°C, followed by a conjugated secondary (sp-0023) for 20 minutes and DAB staining. |
风险提示:丁香通仅作为第三方平台,为商家信息发布提供平台空间。用户咨询产品时请注意保护个人信息及财产安全,合理判断,谨慎选购商品,商家和用户对交易行为负责。对于医疗器械类产品,请先查证核实企业经营资质和医疗器械产品注册证情况。
文献和实验-7表达水平降低(Takamizawa et al., 2004)。在动物体内,let-7的表达依赖于动物的生长发育周期,在发育早期let-7低表达,而分化成熟的组织let-7高表达。下调let-7的表达水平致使分化失败,从而导致了癌症的发生。另外,实验表明,RAS癌基因是miRNA let-7的直接靶点,说明在肺癌发生过程中,let-7通过调节RAS的表达发挥抑癌基因作用。第二种情况,通过作用于抗凋亡基因BCL2靶点,下调miR-15和miR-16在慢性淋巴瘤的表达。另一方面,致癌的miRNAs
。 而用常规的杂交或抗体检测方法来分析它们是极其因难、 甚至是不可能的。RNA/PCR 技术在研究转基因动物方面将非常有用。我们常常不仅要知道在动物体内转移的基因是否表达,而且要知道是在哪些细胞,组织或器官中表达。 随着 RNA/PCR 检测灵敏度的提高,能够检测转基因动物的多个部位而不必为取样 而将它处死。我们还可以列举许多这样的例子,但我们留给读者一些有关检测方面的 设想。 用于诊断的 RNA 序列的扩增在许多情况下,一个特异性的 RNA 分子可作为感染或遗传/癌疾病的诊断。在反转 录病毒疾病领域
相关病毒,发现与人类癌症相关的病毒,并对其进行分类,以指导治疗。(4)检测肿瘤的抑制基因的改变,分析肿瘤发生机理及判断预后。(5)用于肿瘤的抗药性基因分析,为肿瘤的化疗提供选择方案。(6)通过对转移基因及转移抑制基因检测,判断肿瘤有无转移,为手术治疗提供依据。 1. ras -PCR[8 、9] ras 基因家族由H-ras,K-ras 和N-ras 组成。在人类肿瘤中ras 基因激活的主要方式是点突变,而且常位于第12、13、59或61位密码子处,不同的ras 基因在不同的肿瘤具有优势激活
技术资料暂无技术资料 索取技术资料